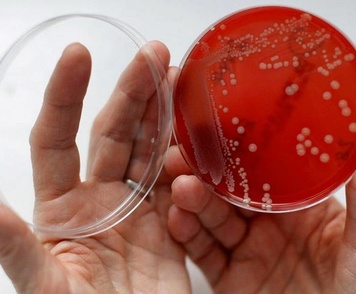
Причины гарднереллеза
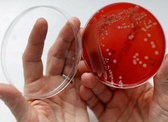
img

Гарднереллез у женщин и мужчин

Женщины в любом возрасте могут иметь бактериальный вагиноз или гарднереллез - редко у подростков и женщин, которые никогда не были сексуально активными. Тем не менее, это чаще встречается среди девушек и женщин, которые занимались сексом с одним или несколькими партнерами.
Что вызывает бактериальный вагиноз ?
Бактериальный вагиноз или гарднереллез - это вагинальная инфекция, вызванная чрезмерным ростом анаэробных бактерий и организма, называемого Gardnerella vaginalis. «Анаэробный» означает, что бактерии не нуждаются в кислороде, чтобы выживать или расти. Небольшие количества этих анаэробных бактерий и гарднерелл обычно находятся во влагалище. Бактериальный вагиноз возникает, когда нарушается баланс организмов во влагалище и разрастаются анаэробные бактерии. Хорошие, защитные бактерии, лактобациллы, тогда проигрывают по численности и не в состоянии выполнять свою обычную работу, то есть производить натуральное дезинфицирующее средство, которое помогает организму поддерживать нормальный, здоровый баланс во влагалище. Когда это происходит, возникает инфекция.
Точные причины разрастания бактерий Gardnerella vaginalis неизвестны. Гарднереллез чаще встречается у женщин, которые имеют несколько половых партнеров. Бактериальный вагиноз также может возникать после полового акта с новым партнером и после спринцевания или других причин, вызывающих изменения соотношения бактерий во влагалище.
Каковы признаки/симптомы бактериального вагиноза (гарднереллеза)?
Это факт, что у 50-75% женщин, у которых есть гарднереллез, нет никаких симптомов, но те, кто часто жалуются на рыбный запах вагинальных выделений и тонкие серовато-белые выделения из влагалища. Урогенитальный секрет может быть незначительным или обильным. Запах может ухудшиться во время менструации или после незащищенного полового акта. Когда сперма (мужская сперма) смешивается с выделениями из влагалища, запах становится сильнее. Менее распространенные симптомы включают: зуд влагалища, покраснение и боль при половом акте.
Ваш лечащий врач может заметить выделения или запах из влагалища во время вашего рутинного гинекологического осмотра и сделать анализ вагинального секрета, чтобы определить, есть ли у вас Gardnerella vaginalis или любые другие вагинальные инфекции. Если у вас есть гарднереллез, ваш лечащий врач даст вам рецепт для его лечения.
Как диагностируется гарднереллез?
Единственный способ диагностировать Gardnerella vaginalis - это обследование у акушера-гинеколога и проверка выделения из влагалища. Ваш гинеколог будет использовать ватный тампон для взятия пробы из влагалища. Кислотность выделений затем измеряется с помощью тест-полосок. Если ваше влагалище менее кислое, чем должно быть (рН более 4,5), это может быть признаком того, что у вас может быть бактериальный вагиноз. Ваш гинеколог может посмотреть на образец под микроскопом. Если нормальных бактерий (лактобацилл) нет, но присутствует много «ключевых» клеток (клеток из влагалищной оболочки, покрытых бактериями), то, скорее всего, у вас бактериальный вагиноз. Ваш лечащий врач проверит, есть ли у вас хотя бы 3 из 4 следующих симптомов:

- тонкие белые выделения;
- ключевые клетки;
- рН> 4,5;
- рыбный запах (от выделения);
Есть также специальные тесты, которые могут помочь поставить диагноз.
Как лечится гарднереллез?
Если у вас бактериальный вагиноз, ваш лечащий врач, скорее всего, даст вам рецепт крема или геля, который вы вводите во влагалище с помощью аппликатора, или рецепт на таблетки, которые вы принимаете внутрь. Вы должны сообщить своему врачу о любых других лекарствах, которые вы принимаете. Если вы используете влагалищный крем или гель, вы НЕ должны использовать тампоны во время лечения, потому что они впитывают лекарство и делают его менее эффективным. Метронидазол или клиндамицин являются двумя наиболее распространенными рецептурными препаратами, назначаемыми для лечения бактериального вагиноза. Оба лекарства эффективны, но вы должны убедиться, что вы принимаете ВСЕ лекарства, чтобы оно заработало. Секнидазол - это таблетка для однократного приема, которая используется для лечения гарднереллеза. Обычно это лекарство стоит дороже, но не более эффективно чем метронидазол или клиндамицин. Многие женщины выбирают вагинальный гель, потому что таблетки могут вызвать тошноту и металлический привкус во рту. Другие предпочитают пероральные препараты, потому что они не хотят вводить крем во влагалище. Оба помогают лечить гарднереллез с одинаковой эффективностью.
Вы НЕ должны спринцеваться и использовать аэрозоли и дезодоранты во влагалище. Хотя они могут помочь скрыть запах, они не вылечат инфекцию и могут усугубить ситуацию.
Презервативы могут помочь снизить вероятность заражения гарднереллезом, если вы сексуально активны, потому что сперма не меняет бактерии во влагалище. Хотя гарднереллез чаще встречается у молодых женщин, имеющих половые контакты со многими партнерами, лечение партнера-мужчины не предотвращает будущие инфекции.
Могу ли я снова получить бактериальный вагиноз?
К сожалению, бактериальный вагиноз часто возвращается, даже если вы принимаете все лекарства и следуете советам своего лечащего врача. Согласно исследованиям, у 30% женщин, которые поправились после лечения, снова был гарднереллез в течение трех месяцев, и более 50% женщин снова имели гарднереллез в течение 12 месяцев. Эксперты не знают точно, почему это происходит. Если ваши симптомы вернутся, обратитесь к врачу. Вам может потребоваться лечение в течение более длительного периода времени.
Может ли бактериальный вагиноз вызвать другие проблемы?
Бактериальный вагиноз может увеличить ваши шансы получить серьезную инфекцию таза, называемую воспалительным заболеванием таза, или инфекцию после операции на влагалище или матке. Это также может увеличить ваши шансы на преждевременные роды (роды до нормальных 9 месяцев).
Есть ли осложнения от бактериального вагиноза, если его не лечить?
В большинстве случаев гарднереллез лечится и не вызывает никаких проблем. Однако есть некоторые риски, о которых вы должны знать. Вы также можете с большей вероятностью получить другие инфекции, передающиеся половым путем.
Гарднереллез может увеличить риск воспалительных заболеваний органов малого таза, которые позже могут вызвать проблемы с фертильностью. Беременные женщины, имеющие гарднереллез, чаще рожают недоношенных детей. Предотвращает ли лечение гарднереллеза во время беременности преждевременные роды, пока неясно. Центр по контролю за заболеваниями рекомендует лечение Gardnerella vaginalis, если у вас есть симптомы или если вам предстоит операция на влагалище или матке.
Могут ли мужчины заболеть гарднереллезомом?
Мужчины не могут получить гарднереллез, потому что у пениса нет такого же тонкого баланса бактерий, как во влагалище женщины. Кроме того, гарднереллез не распространяется как инфекция, передающаяся половым путем. Таким образом не стоит переживать о том, что вы заразите своего мужчину.